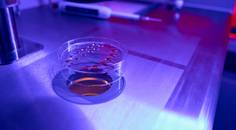
ReachMD Healthcare Image

advertisement
OB/GYN and Women's Health
Articles 241-256 of 306
news.yahoo.com
02/27/2024
biospace.com
02/23/2024
uchicagomedicine.org
02/23/2024
news.northwestern.edu
02/22/2024
cedars-sinai.org
02/21/2024
practicaldermatology.com
02/21/2024- Medical NewsAssociations Between Mango Eaters and Moms-to-Be: Better Diets and Improved Nutrient Intakes
prnewswire.com
02/21/2024
miragenews.com
02/21/2024
cnn.com
02/21/2024- Medical NewsStudy Provides First Evidence of Direct Impact of Serotonin on Development of Prefrontal Cortex
medicalxpress.com
02/20/2024 - Medical NewsOverconsumption of Fructose by Parents Increases Risk of Cardiometabolic Disease in Offspring, Study Shows
medicalxpress.com
02/20/2024
medicalxpress.com
02/20/2024
miragenews.com
02/19/2024
news.weill.cornell.edu
02/15/2024
eurekalert.org
02/15/2024
eurekalert.org
02/15/2024